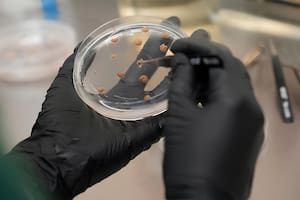
Debido a la disparada en el precio del cacao, los grandes fabricantes de chocolate están apelando a fórmulas no tradicionales para sustituir el producto

Telecom invertirá US$2000 millones en 2025, incluida la compra de Telefónica
La operación aún es analizada por la Comisión Nacional de Defensa de la Competencia; la empresa además desplegará más de 750 sitios 5G en el país
4 minutos de lectura'


El CEO de Telecom Argentina, Roberto Nobile, anunció que la compañía lleva invertidos unos US$2000 millones en lo que va del año —incluida la adquisición de Telefónica— y que, hacia fines de 2025, contará con más de 750 sitios 5G desplegados en todo el país.
El directivo expuso durante el Telecom Summit 2025, un encuentro dirigido a clientes corporativos en el que se debatió sobre el rol de la inteligencia artificial (IA) como herramienta para escalar negocios y transformar procesos productivos.
“No estamos exentos de desafíos. Hoy el contexto en que nos movemos es de disrupciones permanentes, cambios rápidos que afectan la sustentabilidad de los negocios y exigen resiliencia, creatividad y, sobre todo, flexibilidad”, señaló Nobile.
Según el ejecutivo, la Argentina atraviesa una etapa de recuperación macroeconómica que “abre oportunidades” para las empresas capaces de hacer el catch up tecnológico. “No podemos quedarnos solo con la macro. Tenemos que seguir invirtiendo e innovando para que esta recuperación sea sustentable y cree valor hacia adelante”, advirtió.
En esa línea, Nobile recordó que Telecom lleva invertidos más de US$7000 millones en los últimos ocho años y US$2000 millones solo en 2025, incluyendo los US$1245 millones que desembolsó en la compra de Telefónica. “No lo hacemos porque nos gusta despilfarrar la plata, sino porque proyectamos la realidad de las telecomunicaciones y de la conectividad del futuro, que nos obliga a seguir invirtiendo como lo estamos haciendo”, sostuvo.
Consultadas acerca de las inversiones de Telefónica para 2025, fuentes de Telecom dijeron que corren por cuenta de esa compañía y que el dinero proviene de la operación. Este año ascenderían a US$387 millones.
Recientemente, Telecom respondió a las objeciones de la Comisión Nacional de Defensa de la Competencia por la compra de Telefónica y ahora ese organismo debe analizar el escrito y luego convocar a una audiencia destinada a analizar las posibles medidas que mitiguen los potenciales efectos negativos de concentración de la operación sobre la competencia.
Durante su exposición, Nobile también destacó la centralidad de la inteligencia artificial en la estrategia de Telecom.
“La IA trae desafíos a nivel empresa y a nivel conducción. Se tiene que alinear con la visión estratégica y con el negocio. Es fundamental buscar valor real y escalable, con casos de uso que generen impacto. Nosotros ya trabajamos bajo esta premisa con dos focos: la experiencia del cliente —para que reciba un servicio personalizado, eficiente y ágil— y la red, para que sea capaz de autodiagnosticarse y autocorregirse”, explicó.
Y agregó: “En Telecom queremos ser socios estratégicos de nuestros clientes para crear un ecosistema de valor, con empresas más sólidas, resilientes e innovadoras, donde la tecnología sea el motor de un país más conectado, productivo y competitivo”.
Entre los hitos recientes, la compañía destacó el despliegue del primer nodo de la red 5G standalone del país, ya operativo con terminales comerciales. “Era una promesa y hoy es una realidad”, aseguró Nobile, al tiempo que ratificó la meta de cerrar el año con más de 750 sitios 5G activos.
Actualmente, Telecom opera 16 data centers en la Argentina, infraestructura que busca potenciar el uso intensivo de inteligencia artificial y servicios en la nube. De cara a 2033, la firma proyecta que la capacidad de red deberá multiplicarse casi por diez para acompañar la expansión de la IA y garantizar conectividad de alta calidad en todo el país.
1Real hoy: a cuánto cotiza la moneda brasilera oficial y blue este viernes 16 de enero
- 2
PNC: cuál es el monto de las pensiones en febrero de 2026
3Mientras se habla de un récord nacional con el maíz, en el sur cordobés falta agua y el cereal pierde rinde
4“Es la punta del iceberg”: apostaron a un cultivo en boom a nivel mundial y hoy impulsan un nuevo polo productivo en La Pampa